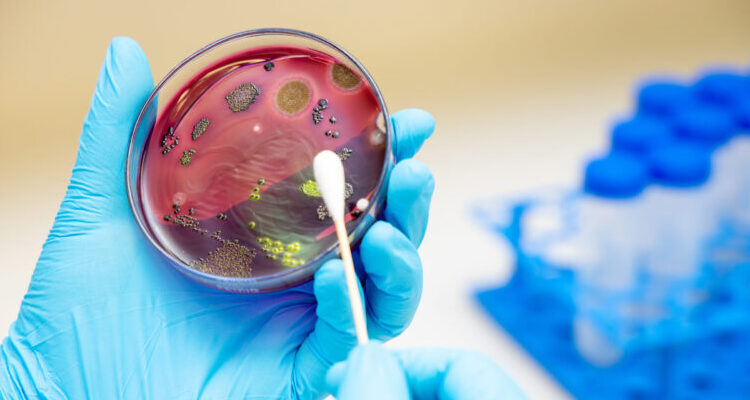

Sanitation in food production and processing facilities can be challenging, and the baking industry is no exception. One common challenge is the presence of hard-to-reach areas and intricate machinery, which can make cleaning difficult. Another challenge is the need for quick turnaround times between production runs, which leaves little time for cleaning.
There are several good practice principles that can help ensure proper sanitation in food production and processing facilities. These include:
- Establishing a sanitation program: A sanitation program should be established that outlines the specific cleaning procedures and schedules for each area of the facility.
- Training employees: Employees should be trained on proper cleaning procedures and the importance of maintaining a clean and sanitized facility.
- Using the correct cleaning agents: The correct cleaning agents should be used for each surface and piece of equipment to ensure that they are properly cleaned and sanitized.
- Maintaining equipment: Equipment should be maintained regularly to ensure that it is functioning correctly and does not pose a risk of contamination.
Cleaning in Place (CIP) is a cleaning method used in the food and beverage industry that allows for the cleaning of equipment and machinery without the need for disassembly. CIP solutions are commonly used in the baking industry to clean mixers, ovens, and conveyors.
These solutions work by circulating cleaning solutions through the equipment using a series of pumps, valves, and pipes. The cleaning solution is then drained, and the equipment is rinsed with water before being put back into operation.
Compared to other cleaning methods, CIP solutions offer several advantages. They are more efficient, as they allow for quick cleaning without the need for disassembly, reducing downtime between production runs. They also reduce the risk of contamination as they eliminate the need for manual cleaning, which can lead to human error.
Digital CIP Optimization for Membrane Filtration
GEA recently announced they were able to reduce water and power consumption during the cleaning of membrane filtration plants by up to 50% with two new digital tools. The software duo, GEA Smart Filtration CIP and GEA Smart Filtration Flush, automatically intervene in CIP processes, pulsing the pumps and flushing the membranes individually and according to real-time water quality.
Membrane filtration plants separate or concentrate substances without thermal stress. Membrane filtration is primarily used in food manufacturing – including new foods – and in dairy processing. Common product examples include dairy protein and fish collagen isolates. Until now, cleaning this equipment was energy- and water-intensive, requiring three or four individual cleaning steps with different chemical cleaning agents to be pumped and circulated throughout the equipment for a specified amount of time before rinsing it out with water.
In contrast, GEA Smart Filtration Flush uses sensors to constantly measure the permeate quality of the water during the flushing process, reducing the freshwater required. Setting blanket rinsing intervals and water quantities in advance are no longer needed as the software stops the process as soon as the necessary hygiene level is reached, and the cleaning agents are discharged. Depending on the type and size of the plant and the water properties, operators can reduce their freshwater requirements by up to 50%.
Water-saving CIP Optimization, Downsized CIP Infrastructure
“A typical dairy whey protein concentration process needs two to four filtration plants connected in a series. This set up can require more than 100,000 liters of water, per cleaning cycle,” explains Nils Mørk, R&D Engineer for membrane filtration at GEA. “Today, we know from plant tests that we can save well up to 50,000 liters of water per cleaning in such large plants and 500 to 700 liters per CIP in small productions.”
You can read the rest of this article in the March-April issue of European Baker & Biscuit, which you can access by clicking here.